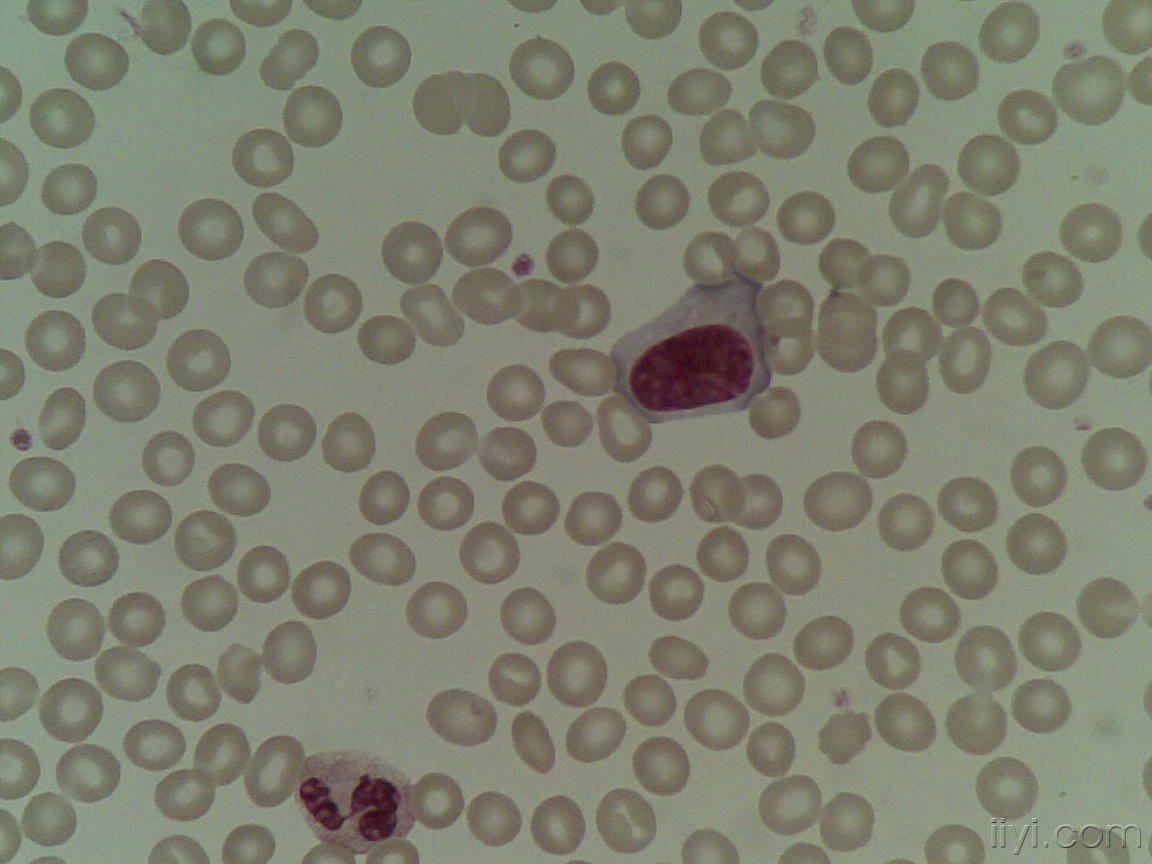
血片中的异型淋巴细胞 (一)

异淋细胞

求异型淋巴细胞三种类型的多组图片及解析
图片尺寸2592x1936
异型淋巴细胞图谱
图片尺寸693x462
《异型淋巴细胞》课件
图片尺寸800x450
日本血液学会的异型淋巴细胞图片
图片尺寸800x600
异型淋巴细胞反应性淋巴细胞
图片尺寸1920x1870
血片中的异型淋巴细胞 (一)
图片尺寸1152x864
血片中的异型淋巴细胞 (一)
图片尺寸1152x864
日本血液学会的异型淋巴细胞图片
图片尺寸800x600
其它 异淋 其中有其他单核,淋巴,骨髓瘤细胞.要有鉴识.不然……!
图片尺寸509x810
大家看看异型淋巴细胞
图片尺寸460x307
推片镜检可见异常淋巴细胞
图片尺寸1199x1599
异型淋巴细胞图谱
图片尺寸750x750
血片中的异型淋巴细胞 (一)
图片尺寸1152x864
外周血异型淋巴细胞及鉴别ppt模板
图片尺寸1200x7580
20181207夜班
图片尺寸2000x2000
大家看看异型淋巴细胞
图片尺寸600x800
异型淋巴增高为哪般
图片尺寸583x678
日本血液学会的异型淋巴细胞图片
图片尺寸800x600
其它 异淋 异:异淋 正:正常淋巴
图片尺寸587x810
日本血液学会的异型淋巴细胞图片
图片尺寸800x600